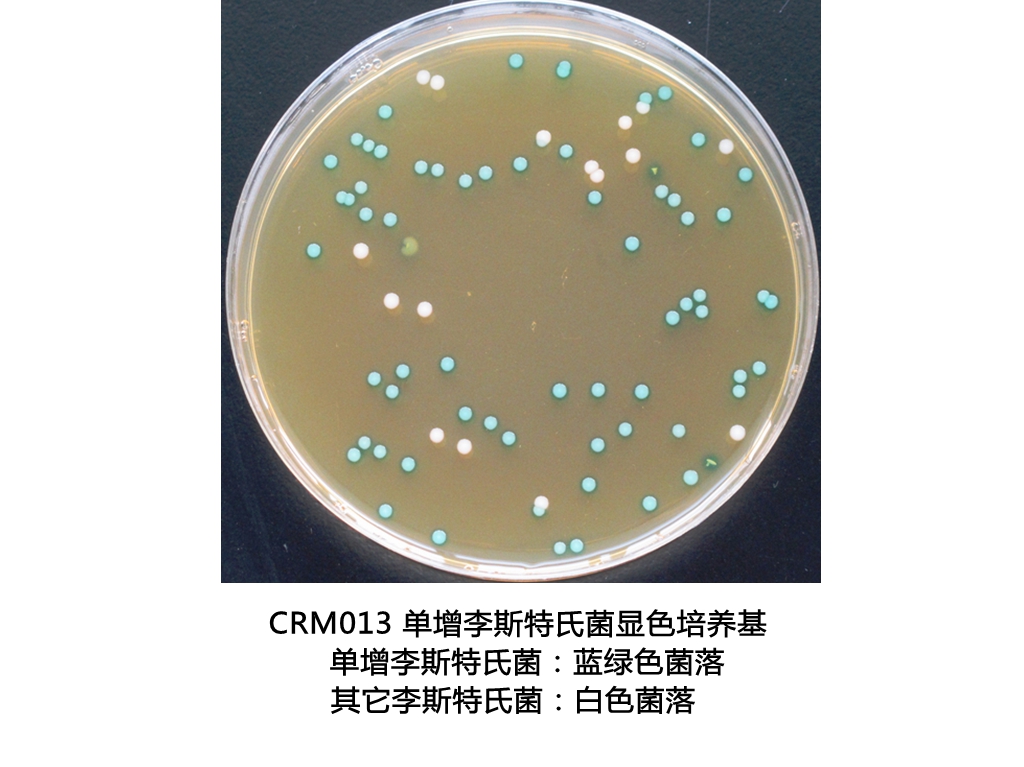
单增李斯特氏菌显色培养基平板生物图册

相关产品推荐更多 >
万千商家帮你免费找货
0 人在求购买到急需产品
- 详细信息
- 文献和实验
- 技术资料
- 库存:
9999
- 英文名:
Chromogenic L.monocytogenes Agar Plate
- 保质期:
见产品标签
- 供应商:
广东环凯官方厂家
- 保存条件:
2-8℃,贮存于避光处
- 规格:
90mm×20个/盒
产品名称:单增李斯特氏菌显色培养基平板
英文名称:Chromogenic L.monocytogenes Agar Plate
其他叫法:单增李斯特氏菌显色平板 | 单增李斯特氏菌显色琼脂平板培养基
产品编号与包装规格:
| 产品编号 | 产品类型 | 包装规格 |
| CRM013P1 | 即用型成品平板 | 20套/盒(φ9cm) |

产品用途:用于单增李斯特菌的分离和初步鉴别。
使用方法:在洁净环境,打开包装即可使用,需注意无菌操作。
质量控制:(下列质控菌株接种后于35~37℃培养24±3h,观察结果如下表:)
| 指标 | 质控菌株及编号 | 标准值 | 特征性反应 |
| 生长率 | 单增李斯特氏菌ATCC19115 | PR≥0.7 | 蓝绿色光滑规则小菌落 |
| 特异性 | 英诺克李斯特氏菌ATCC33090 | —— | 无色光滑规则小菌落 |
| 选择性 | 大肠埃希氏菌ATCC25922 | G≤1 | —— |
| 粪肠球菌ATCC29212 | |||
| 白色念珠菌ATCC10231 |
产品更多介绍详见 CRM013 单增李斯特氏菌显色培养基 干粉 1000mL
单增李斯特氏菌显色培养基平板 相关显色培养基产品目录 :
| 产品货号 | 产品名称 | 产品规格 | 产品用途 |
| CRM013 | 单增李斯特氏菌显色培养基 | 1000mL/瓶 | 用于分离和初步鉴别单增李斯特氏菌 |
| CRM014 | 李斯特氏菌显色培养基 | 1000mL/瓶 | 用于分离和初步鉴别单增李斯特氏菌和其它李斯特氏菌 |
| CRM014P1 | 李斯特氏菌显色培养基平板 | 90mm×20个/盒 | |
| CRM017 | 克罗诺杆菌显色培养基 | 1000mL/瓶 | 主要用于婴儿奶粉以及其他食品中的克罗诺杆菌属(阪崎肠杆菌)的初步鉴别和计数 |
| CRM001 | 大肠菌群显色培养基 | 1000mL/瓶 | 24 小时平板法快速检测大肠菌群 |
| CRM001A | 大肠菌群显色培养基平板 | 90mm×20个/盒 | |
| CRM002 | 大肠杆菌显色培养基 | 1000mL/瓶 | 24 小时平板法快速检测大肠杆菌 |
| CRM002A | 大肠杆菌显色培养基平板 | 90mm×20个/盒 | |
| CRM003 | 大肠菌群大肠杆菌(ECC)显色培养基 | 1000mL/瓶 | 24 小时平板法快速检测大肠菌群大肠杆菌 |
| CRM003A | 大肠菌群大肠杆菌(ECC)显色培养基平板 | 90mm×20个/盒 | |
| CRM004 | 沙门氏菌显色培养基 | 1000mL/瓶 | 用于沙门氏菌的分离和初步鉴定 |
| CP0560 | 沙门氏菌显色培养基平板 | 90mm×20个/盒 | |
| CRM005 | 蜡样芽胞杆菌显色培养基 | 1000mL/瓶 | 用于蜡样芽孢杆菌的选择性分离和初步鉴别 |
| CRM005A | 蜡样芽孢杆菌显色培养基平板 | 90mm×20个/盒 | |
| CRM006 | 阪崎肠杆菌显色培养基(DFI琼脂) | 1000mL/瓶 | 主要用于婴儿奶粉以及其他食品中的阪崎肠杆菌的快速鉴定和计数 |
| CRM006B | 阪崎肠杆菌显色培养基(DFI琼脂)平板 | 90mm×20个/盒 | |
| CRM007 | 大肠杆菌O157:H7显色培养基 | 1000mL/瓶 | 用于大肠杆菌 O157:H7 的快速分离和鉴定 |
| CRM007B | 大肠杆菌O157:H7显色培养基平板 | 90mm×20个/盒 | |
| CRM008 | 弧菌显色培养基 | 1000mL/瓶 | 用于弧菌特别是副溶血性弧菌的分离和初步鉴定 |
| CP0570 | 弧菌显色培养基平板 | 90mm×20个/盒 | |
| CRM009 | 霍乱-弧菌显色培养基 | 1000mL/瓶 | 用于霍乱-弧菌的快速分离和初步鉴别 |
| CRM009B1 | 霍乱-弧菌显色培养基平板 | 90mm×20个/盒 | |
| CRM010 | 念珠菌显色培养基 | 1000mL/瓶 | 用于念珠菌特别是白色念珠菌的选择性分离和初步鉴别 |
| CRM010P1 | 念珠菌显色培养基平板 | 90mm×20个/盒 | |
| CRM016 | 念珠菌显色培养基(20版药典) | 1000mL/瓶 | |
| CRM011 | 志贺氏菌显色培养基 | 1000mL/瓶 | 用于金黄色-葡萄球菌的分离和初步鉴别 |
| CRM011A | 志贺氏菌显色培养基平板 | 90mm×20个/盒 | |
| CRM012 | 金黄色-葡萄球菌显色培养基 | 1000mL/瓶 | 用于金黄色-葡萄球菌的分离和初步鉴别 |
| CRM012A | 金黄色-葡萄球菌显色培养基平板 | 90mm×20个/盒 |
风险提示:丁香通仅作为第三方平台,为商家信息发布提供平台空间。用户咨询产品时请注意保护个人信息及财产安全,合理判断,谨慎选购商品,商家和用户对交易行为负责。对于医疗器械类产品,请先查证核实企业经营资质和医疗器械产品注册证情况。
文献和实验环凯提供GB4789系列标准文献及更多微生物检查相关国家标准、药典标准、国外标准等文献进行查阅下载!

1 主题内容与适用范围本文规定了食品中沙门氏菌的检验方法。本文适用于航空食品的检验。2 设备和材料吸管(1ml、10ml)、恒温培养箱(36±1℃、42℃)、冰箱、均质器、振荡器、平皿、稀释瓶、天平、显微镜、接种棒等3 培养基和试剂缓冲蛋白胨水(BP)、氯化镁孔雀绿增菌液、四硫酸钠煌绿(TTB)增菌液、亚硒酸盐胱氨酸(SC)增菌液、亚硫酸铋琼脂(BS)、DHL琼脂、HE琼脂、WS琼脂、SS琼脂、三糖铁琼脂、蛋白胨水、靛基质试剂、尿素琼脂(pH7.2)、氰化钾(KCN)培养基、氨基酸脱羧酶试验
菌种活化:干粉标准菌株 标准贮备菌株 工作菌株; 1.1 金黄色葡萄球菌、大肠埃希氏菌、铜绿假单胞菌、枯草芽孢杆菌标准菌株: 挑取部分干粉溶解于0.9% 无菌氯化钠溶液中,划线接种于营养琼脂平板上,36℃±1℃ 培养18-24 小时。并观察菌落形态。 a. 金黄色葡萄球菌:菌落凸起,圆形,不透明; b. 大肠埃希氏菌:菌落稍凸,圆形,湿润,乳白色; c. 铜绿假单胞菌:菌落扁平,圆形,边缘不整齐,光滑湿润,可产生蓝绿或黄绿色素; d. 枯草芽孢杆菌: 表面粗糙不透明
基反应可生成红色化合物。 为了获得有效的实验数据,实验菌种选用CICC,21633单增李斯特氏菌(以下简称单增菌),质控菌种选用CICC,10041蜡样芽孢杆菌(以下简称蜡样菌),V-P培养基选用同一厂家、同一批次、且在有效期内的生化管。 蜡样菌V-P培养基培养24h,滴加甲、乙液后30min内呈现阳性,证明试验用V-P培养基无质量问题。单增菌V-P培养基分别于30℃和37℃培养24h、48h、72h、96h,实验结果如下表。通过实验我们发现两种现象。其一,单增菌培养的时间
技术资料










